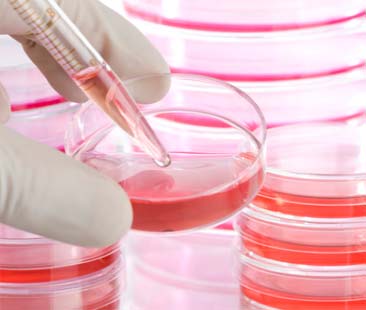
Metodo Stamina, bocciatura. “Un’eutanasia di Stato”

CATANIA – Un tragico incidente in motorino nel 2003, le gravi lesioni cerebrali, la diagnosi di stato vegetativo permanente e il risveglio, inatteso, incredibile, miracoloso. La storia di Salvatore Crisafulli, catanese, la conosciamo tutti. Conosciamo bene il suo sguardo, la sua voglia di vivere e la profondità dei suoi occhi, capaci di vincere il coma e far dimenticare anche la successiva sindrome “locked in”.
Una storia di gioia e amarezze, battaglie e richieste. Una storia di vita ma anche di abbandono, perché Salvatore è scomparso il 21 febbraio di quest’anno, a 47 anni, portando con sé tante cose da recriminare alle istituzioni di questo Paese. Accanto a lui, per anni, il fratello Pietro, presidente dell’Associazione Sicilia risvegli onlus e vicepresidente del Movimento vite sospese, che si è reso punto di riferimento non solo per Salvatore, assistendolo senza sosta negli anni della malattia, ma anche per tutte quelle persone che vivono in solitudine la loro condizione di disabilità.
Perché parlare di difesa della vita è facile, ma quando le parole devono tramutarsi in fatti il deserto si fa strada. Desertificazione dell’anima, forse. Tra le tante battaglie di Pietro Crisafulli, una in particolare ha destato il forte interesse delle istituzioni, della piazza e dei media: l’accesso al metodo terapeutico Stamina, finalizzato in particolare alla cura di gravi malattie neurodegenerative e promosso dalla Stamina foundation onlus di Davide Vannoni. Abbiamo intervistato Pietro Crisafulli per conoscere alcuni profili della sua attività pro Stamina.
Presidente Crisafulli, la storia del metodo Stamina si può considerare, in qualche modo, una storia “siciliana”?
“Senz’altro. La storia di Smeralda Camiolo parla da sé. Una bambina catanese di due anni che dalla nascita non aveva mai lasciato l’ospedale (a causa di un gravissimo problema durante il parto che le ha causato il coma) e, grazie alle cure del metodo Stamina, ha potuto finalmente vedere casa sua per la prima volta. Contiamo attualmente quasi trecento persone che, solo nella nostra regione, chiedono l’accesso alla cura con le staminali. La maggior parte sono bambini con patologie molto gravi. Di recente, il Tribunale di Catania ha riconosciuto a un malato di Sla il diritto a curarsi, e il Tribunale di Messina ha fatto lo stesso con un caso di paralisi infantile. Grazie anche agli accordi con l’ospedale “Ferrarotto” di Catania e il “Cervello” di Palermo, mi aspetto una svolta epocale: la Sicilia (e Catania in particolare) finalmente protagonista”.
“Senz’altro. La storia di Smeralda Camiolo parla da sé. Una bambina catanese di due anni che dalla nascita non aveva mai lasciato l’ospedale (a causa di un gravissimo problema durante il parto che le ha causato il coma) e, grazie alle cure del metodo Stamina, ha potuto finalmente vedere casa sua per la prima volta. Contiamo attualmente quasi trecento persone che, solo nella nostra regione, chiedono l’accesso alla cura con le staminali. La maggior parte sono bambini con patologie molto gravi. Di recente, il Tribunale di Catania ha riconosciuto a un malato di Sla il diritto a curarsi, e il Tribunale di Messina ha fatto lo stesso con un caso di paralisi infantile. Grazie anche agli accordi con l’ospedale “Ferrarotto” di Catania e il “Cervello” di Palermo, mi aspetto una svolta epocale: la Sicilia (e Catania in particolare) finalmente protagonista”.
Come avete reagito alla bocciatura radicale del metodo da parte del comitato scientifico del ministero della Salute?
“Ce lo aspettavamo, perché del comitato fanno parte persone che si sono sempre espresse contro il metodo Stamina. Abbiamo più volte chiesto il contradditorio con queste persone, compresa anche il ministro Lorenzin, ma senza successo. Per di più si rifiutano di incontrare i malati, di guardare con i propri occhi la sofferenza di queste persone. Il provvedimento è illegittimo, non escludo una possibile denuncia. Inoltre, ho suggerito personalmente a Vannoni di provare una sperimentazione all’estero”.
“Ce lo aspettavamo, perché del comitato fanno parte persone che si sono sempre espresse contro il metodo Stamina. Abbiamo più volte chiesto il contradditorio con queste persone, compresa anche il ministro Lorenzin, ma senza successo. Per di più si rifiutano di incontrare i malati, di guardare con i propri occhi la sofferenza di queste persone. Il provvedimento è illegittimo, non escludo una possibile denuncia. Inoltre, ho suggerito personalmente a Vannoni di provare una sperimentazione all’estero”.
A proposito di sperimentazione all’estero, qualcuno parlava di un collegamento tra Vannoni e Medestea, multinazionale leader della cosmetica, interessata a un’ampia deregolamentazione in materia di staminali. Conferma?
“Si, sono in contatto, è vero, ma non mi risulta ci siano accordi particolari in cantiere”.
“Si, sono in contatto, è vero, ma non mi risulta ci siano accordi particolari in cantiere”.
Il metodo proposto da Vannoni ha comunque dei costi rilevanti: si parla di 30-50 mila euro. Sono notizie corrette?
“Parzialmente corrette, perché le cinque infusioni per completare il ciclo in laboratori Glp (secondo le norme di “buona pratica di laboratorio”) in realtà non costano più di settemila euro. Fuori dal sistema Glp i costi effettivamente aumentano. Ci terrei però a precisare, a proposito di costi, che un malato in stato vegetativo ricoverato nelle strutture statali rappresenta un costo di circa 300 mila euro annui. La rianimazione pediatrica, invece, costa alle strutture più di tremila euro annui per ogni singolo paziente. Sono tutti dati tratti dalla farmacoeconomia che ho presentato alla commissione Sanità della Regione siciliana. Anche sulla base di questi dati la Regione ha deciso di approvare la risoluzione che individua i due ospedali abilitati al trattamento con Stamina”.
“Parzialmente corrette, perché le cinque infusioni per completare il ciclo in laboratori Glp (secondo le norme di “buona pratica di laboratorio”) in realtà non costano più di settemila euro. Fuori dal sistema Glp i costi effettivamente aumentano. Ci terrei però a precisare, a proposito di costi, che un malato in stato vegetativo ricoverato nelle strutture statali rappresenta un costo di circa 300 mila euro annui. La rianimazione pediatrica, invece, costa alle strutture più di tremila euro annui per ogni singolo paziente. Sono tutti dati tratti dalla farmacoeconomia che ho presentato alla commissione Sanità della Regione siciliana. Anche sulla base di questi dati la Regione ha deciso di approvare la risoluzione che individua i due ospedali abilitati al trattamento con Stamina”.
Nonostante il blocco del comitato ministeriale, chi ha avuto riconosciuto il diritto alle cure potrà continuare il trattamento?
“Sì, ma si tratta di una discriminazione inaccettabile. Le liste d’attesa sono interminabili e stiamo contando praticamente una vittima al mese. Questa è eutanasia di Stato".
“Sì, ma si tratta di una discriminazione inaccettabile. Le liste d’attesa sono interminabili e stiamo contando praticamente una vittima al mese. Questa è eutanasia di Stato".